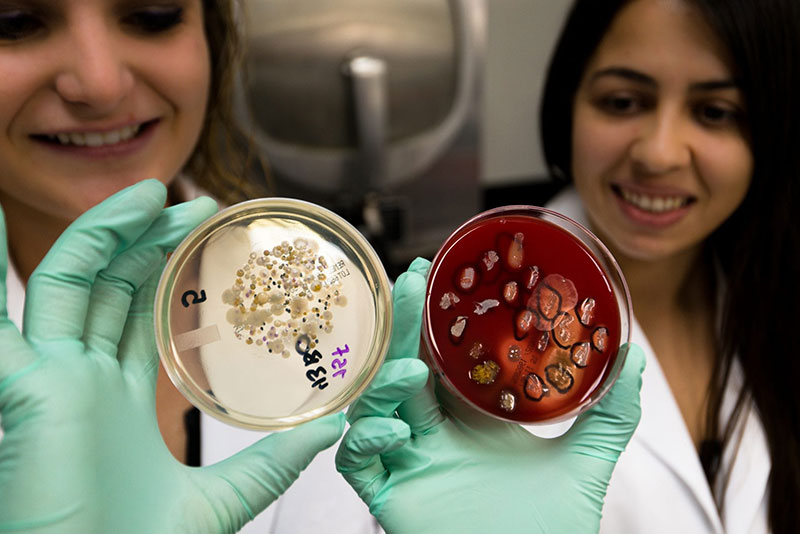

Editor’s Note: Dr. Jane Harrington is Assistant Professor of Microbiology and Immunology at UMHS. This blog post is about the accomplishments of the first UMHS Medical Research Elective class (for which Dr. Harrington is Course Director) in Spring 2015 at UMHS, one of the leading Caribbean medical schools.
By Dr. Jane Harrington
The Spring 2015 semester was a busy time for the students enrolled in the first-time offered UMHS Medical Research Elective course. The class met on a weekly basis to develop writing skills and to present project proposals and journal articles. In addition to course work, each student pursued an independent research project described below and collaborated with AMSA to conduct a Blood Typing lab session.

UMHS MEDICAL RESEARCH ELECTIVE CLASS MEMBERS: (left to right) Bernadette Schmidt, Victoria Gonzalez, Laura Mena-Albors & Wined Ramirez. Photo: Ian Holyoak
EBS5 students Victoria Gonzalez and Bernadette Schmidt completed all data collection and analysis for the UMHS Surface Microbial Contaminant project, continuing from their work from last semester. Their findings characterized over 200 bacterial isolates from 100 unique sites on campus, including predominant frequency of Staphylococcus epidermis. Of medical concern, 30 sampled locations yielded Staphylococcus aureus isolates, including 7 Methicillin-Resistant Staph aureus (MRSA) cultured from faucet and paper towel handles in both men and women’s bathrooms outside Auditorium. The team have successfully drafted an original journal article, which is planned for submission in early fall.
UMHS STUDENTS IN THE LAB: (left) Bernadette Schmidt & Victoria Gonzalez (right) 'The plate on the left is what we cultured from water samples from faucet in Western lab classroom, captured on a filter,' says Dr. Harrington. Photo: Ian Holyoak
EBS4 students Katie Plemmons and Geneviève Aubé investigated microbial loads on 60 personal data devices of students, including cell phones and tablets before and after use of alcohol swabs. All devices showed microbial contamination, regardless of cleaning. Of interest, the fungal counts were much higher than previous comparable studies, most likely due to the warm tropical environment, which is conducive to fungal growth. Although alcohol cleaning reduced fungal loads (~27% reduction), some bacterial species were over-represented post-cleaning (~38% increase). These findings suggest that an alternative method should be utilized to disinfect phones.

EBS3 UMHS STUDENTS: (left) Wined Ramirez & (right) Laura Mena-Albors. Photo: Ian Holyoak
EBS3 students Laura Mena-Albors and Wined Ramirez initiated a public outreach project, teaching children about hand hygiene and the presence of microbes on surfaces. The team visited SKI Academy to work with a group of kindergarten students and invited a group of teens from St Kitts Youth Leadership camp to the UMHS campus. The lessons include instructing students about the differences between bacteria and fungi and the differences between beneficial and harmful microbes. The activities include testing a hypothesis of the most effective hand-cleaning and surface-cleaning methods with sampling and culturing environmental microbial samples, which engages students in the Scientific Process. Of note, Dr. Harrington’s daughter Sara Jane joined in the fun!

UMHS STUDENT SAMAH HALBOUNI: Analyzed the incidence of mosquito-borne tropical diseases to develop a project plan for an epidemiological student that determines risk for medical students in the Caribbean. Photo: Ian Holyoak
EBS2 student Samah Halbouni analyzed the incidence of mosquito-borne tropical diseases to develop a project plan for an epidemiological student that determines risk for medical students residing in the Caribbean. In theory, medical students can contract Chikagunya virus in St Kitts, travel to states like Florida where Aedes mosquito is endemic, and further transmit the tropical disease. Furthermore, Samah hypothesizes that Puerto Rican students with a history of Dengue disease are at risk of contracting a different serotype of Dengue virus that is present in St Kitts, thus putting them at risk of Dengue Hemorrhagic Disease. The study will be conducted via anonymous questionnaire next fall.

TEACHING KIDS AT SKI ACADEMY: UMHS student Laura Mena-Albors working with some future scientists. Photo: Ian Holyoak

UMHS STUDENTS GIVING LESSON AT SKI ACADEMY: Laura Mena-Albors (left) and Wined Ramirez (right). Photo: Ian Holyoak

LEARNING ABOUT BACTERIA & FUNGI: Sara Jane Harrington (Dr. Harrington's daughter) was among the children at SKI Academy who learned about the differences between bacteria & fungi & the differences between beneficial & harmful microbes. Photo: Ian Holyoak
(Top photo) FIRST UMHS RESEARCH ELECTIVE CLASS (left to right) Katie Plemmons, Wined Ramirez, Samah Halbouni, Laura Mena-Albors, Victoria Gonzalez, Bernadette Schmidt, Geneviève Aubé & Dr. Jane Harrington. Photo: Ian Holyoak
About UMHS:
Built in the tradition of the best US universities, the University of Medicine and Health Sciencesfocuses on individual student attention, maintaining small class sizes and recruiting high-quality faculty. We call this unique approach, “personalized medical education,” and it’s what has led to our unprecedented 96% student retention rate, and outstanding residency placements across the US and Canada. UMHS is challenging everything you thought you knew about Caribbean medical schools.

Dr. Jane Harrington is a noted microbiologist and former professor at UMHS.







